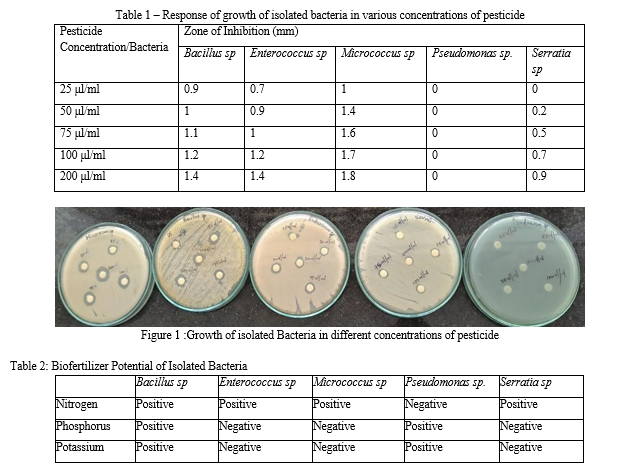

Ijraset Journal For Research in Applied Science and Engineering Technology
Authors: Fousiya M.B, Dr Nisy S.
DOI Link: https://doi.org/10.22214/ijraset.2023.52754
Certificate: View Certificate
Soil loaded with millions of microorganisms forms the most important medium for the survival, growth and multiplication of microorganisms along with plant growth promotion. Understanding the importance of soil micro flora will enable us to learn deeply about soil ecosystem which could be effectively utilized in agricultural practices. The quantity of production is increased gradually by treating large variety of chemical pesticides, which also inhibits the useful microorganisms present in the soil. Chemical pesticides kills the useful bacteria, nematodes, earthworms also causing health effects to people. In this study the soil samples were collected from tomato farms of Erutheympathy where chemical pesticides is used. Total heterotopic population were determined and predominant bacteria were identified as genus Bacillus, Pseudomonas, Serratia, Micrococcus and Enterococcus. After studying pesticide resistance property Pseudomonas found to be resistant to pesticide followed by Serratia. After analysing the bio fertilizer potential for NPK of isolated bacteria Bacillus and Pseudomonas found to solubilize Phosphorus and Potassium. Bacillus, Serratia, Micrococcus and Enterococcus found to have role in conversion of nitrogen which can be absorbed by plants. Unique combination of the soil bacteria with pesticide resistance and bio fertilizer property is a boon to farmers since soil fertility can be retained even after application of chemical pesticide. Key Words: Tomato, Pesticides, Bio fertilizers
I. INTRODUCTION
The tomato (Solanum lycopersicum) is one of the most widely grown vegetable in the world (Ganeshan and Chethana et al., 2009). India is the second largest tomato growing country after China in area (8.65 lakh ha) and production (168.26 lakh tons). The tomato is known for its nutritive value and combined in many different dishes and eaten in different ways as a fresh vegetable or made into soup or sauce. Eating tomatoes has been promoted as helping to prevent human diseases and improving the immune system response (Ntonifor et al., 2013).
Varieties of tomatoes include Meghadoot, Santo, Shivam, Ahalya etc. Erunthieanpathy (10.7503° N, 76.8779° E) which is near to Palakkad, is one of the main district of Kerala where tomato is widely grown.. Tomato is of great importance to the small holders in the district in terms of income generation and local consumption. (G.Keshavareddy et al.,2018). In order to maintain the huge amount of agricultural production, with the application of high-yielding-seeds and proper fertilizers, huge amount of quality pesticides have also been used. The excessive application of pesticides also leads to the accumulation of huge amounts of pesticide in soil and water affecting food chain and drinking water. Various studies suggested that a wide range of microorganisms are capable of degrading pesticides (Rani, M. S. et al.,2008. ). Organophosphorous insecticides such as parathion, methamidophos and chlorpyrifos are a group of highly toxic agricultural chemicals widely used in plant protection.
The contamination has been found up to about 24 km away from the point of use. If pesticides are not degraded or detoxified rapidly, the risk of their off-site migration may pose a health risk to humans and other beneficial soil microorganisms.Some of the microorganism have the ability to degrade pesticides includes Pseudomonas can resist or degrade the chlopyrifos. Biofertilizer is a product that contains living microorganisms, which exert direct or indirect beneficial effects on plant growth and crop yield through different mechanisms.
Most of the Pseudomonas sp shows pesticide resistance and biofertilizer potentials ,these charecteristics of Pseudomonas sp enhance the production of agriculture field These bacteria are great interest as they have been proposed as inoculants for agriculture.
II. MATERIAL AND METHODS
A. Sample Collection
B. Determination Of Physiochemical Properties Of Soil
Physiochemical properties of fresh soil samples pH, EC, available nutrients (NPK kg/ha) were determined at soil testing laboratory, Kerala Forest Research Institute, Peechi, Thrissur, Kerala.
C. Enumeration Of Bacteria From Soil
The soil bacteria were isolated and enumerated by serial dilution technique and spread plate technique on nutrient agar medium .One gram of soil sample were suspended in 9ml of distilled water and mixed well for 15 minutes. Suspension was serially diluted from 10-2 to 10-?.From the diluted sample.0.1 ml was pipetted out on to sterile nutrient agar plates and spread with a sterile glass L rod. Plates were incubated at 37 0 C for 24 hours. The number of colony forming units were counted.Colonies with different morphologies were counted and subcultured. The isolated colonies were maintained at 40C for further studies (Murugalatha et al.,2018).
D. Determination Of Pesticide Resitant Bacteria
Effect of pesticide on growth of microbes and their interaction
Pesticide chlorpyrifos was selected since tomato farmers were using this chlorpyrifos pesticide in tomato fields continuously. Effect of different concentrations of pesticide on isolated soil bacteria was determined by disc diffusion technique.(Bauer et al., 1966) (Mallik and Tesfai et al., 1983)( Martensson et al., 1992). Chlorpyrifos insecticide was obtained from the market. Various concentrations of pesticide were prepared using sterile distilled water (25,50,75,100,200μl/ml). The sterilized discs were dipped in different concentrations of pesticides and kept on sterile Muller Hinton agar plates swabbed with 24 hour old cultures of isolated soil bacteria. For control antibiotic disc and a sterile disc dipped in sterile distilled water was kept on Muller Hinton agar plates inoculated with isolated soil bacteria. The plates were then incubated at 30 °C for 48 hours. After 48 hours, the plated were observed for zones of inhibition around the discs .(Jay Prakash Verma et al.,2016)
E. Determination Of Bio Fertilizer Potential Of Isolated Bacteria
The isolated soil bacteria were inoculated into the Pikovskaya’s agar plates. The plates were incubated at 30 °c for 7 days. The strains with clear zone surrounding the colony indicates the phosphate solubilisation. The diameter of the solubilisation zone is measured and tabulated. (Nautiyal 1999, Wang, Y.et al ;2020).
2. Determination of Potassium solubilising property of isolated soil bacteria
The isolated soil bacteria were inoculated in Aleksandrov medium. The plates were incubated at 30 °c for 7 days. The colonies surrounded with clear zones indicating Potassium solubilisation were selected and diameter of the solubilisation zone is measured and tabulated. (Hassan Etesami et al;2017).
3. Determination of Nitrification property of isolated soil bacteria
The nitrate reduction test is a qualitative procedure for determining the ability of bacteria to reduce nitrate into nitrite. Bacteria were cultured overnight in nitrate broth (HiMedia Labs, Mumbai, India) at 37 °C and then tested for the presence of nitrite. Nitrite detection is a two-step process whereby the reduction of nitrate to nitrite is determined by the addition of nitrate reagent A (sulfanilic acid) followed by reagent B (alpha-napthylamine). If a red color develops, this then confirms the presence of nitrite. If there is no color change, then either nitrate remains unreduced and is determined by the addition of zinc powder which is a strong reducer that will reduce nitrate to nitrite to turn the culture red, confirming there was unreduced nitrate in the tube and then further reduced to other nitrogen compounds. (Arjun Bhusal et al;2021).
III. RESULT
The collected soil were having a texture of sandy clay loam and light brown in colour.After analysing the Physiochemical properties of soil samples pH is found to be 6.7, Electro Chemical Conductivity 0.00039 (dS/m). and available nutrients Nitrogen is 317.36 kg/ha, Phosphorous is 452.45 kg/ha and Pottasium is 498.40 kg/ha. The total hetero tropic bacteria from soil was 150 X 10 3 per gram of soil with 5 different colonies . The predominant bacteria present in the soil of tomato farm were identified as genus Bacillus, Pseudomonas, Serratia, Micrococcus and Enterococcus.We have tested the effect of this pesticide on different concentration on soil bacteria Pseudomonas, Bacillus, Enterococcus, Serratia , Micrococcus by disc diffusion technique. The growth inhibition test was performed at different concentrations of pesticide 25,50,75,100,200 μl/ml. The bacteria Micrococcus, Serratia, Bacillus, and Enterococcus shows zone of inhibition and Pseudomonas does not shows the zone of inhibition indicating it can grow in the presence of pesticide(Table 1). Bacillus, Serratia, Micrococcus, Enterobacter shows the zone of inhibition in different concentrations. Micrococcus found to be highly sensitive to pesticide.After analysing the biofertilizer potential of five isolated bacteria all the bacteria found to possess at least one biofertilizer potential(Table 2). Bacillus found to solubilize Phosphorus and Pottasium along with conversion of nitrate to nitrite. Enterococcus, Micrococcus and Serratia found to have role in nitrogen cycle. Pseudomnas found to solubilize Phosphorus and Pottasium.(Figure:1)
IV. DISCUSSION
Comparing these five organism Pseudomonas sp and Bacillus sp both of them are the best biofertilizer properties. Pseudomonas also found to be resistant to higher concentration of pesticide. This unique property of Pseudomonas with pesticide resistance and biofertilizer potential makes the organism farmer friendly and can be used widely.
The present study reports the identification of bacterium Pseudomonas, which is capable of utilizing chloropyrifos as a source of carbon. Utilisation of xenobiotic compounds by soil microorganisms is a crucial phenomenon by which these compounds are removed from the environment, thus preventing environmental pollution. Results from the present study suggest that the isolated Pseudomonas sp is able to grow in medium in presence of added pesticide and may therefore be used for bioremediation of pesticide contaminated soil. Based on our work, bio fertilizers can be developed using species of Pseudomonas sp ,Serratia sp,Micrococcus sp,Enterococcus sp, Bacillus sp were isolated from soil .Pseudomonas sp and Bacillus sp are phosphate and potassium solibilising bacteria. Serratia sp,Micrococcus sp,Enterococcus sp are nitrate reducing bacteria.These study indicate a significant increment in the productivity of plants treated with newly developed biofertilizers.It is necessary to continue researching in this field as it has the potential to be highly profitable for farmer as well as provide a way to more suitable future.
[1] Biodegradation and bioremediation ,M Alexander 1999 [2] Bioefficiency of pyraclostrobin 25%EC against early blight of tomato,Girija Ganeshan,B.S.Chethana [3] Developing an integrated management approach for fruit fly Dacus punctatifrons on tomatoes,NNntonifor,DNS Nsobineyui,Eric B Fokam,LUM A Fontem. [4] Impact of pesticides use in agriculture: their benefits and hazards,W Aktar, D Sengupta, A Chowdhury . [5] Isolation and characterization of a chlorpyrifos degrading bacterium from agricultural soil and its growth response,MS Rani, KV Lakshmi, PS Devi, RJ Madhuri… - Afr J Microbiol . [6] Isolation and characterization of a chlorpyrifosdegrading bacterium from agricultural soil and its growth response-M. Surekha Rani1, K.Vijaya Lakshmi1* P. Suvarnalatha Devi1,R.Jaya Madhuri1, S. Aruna1,K.Jyothi1,G.Narasimha2andK.Venkateswarlu3. [7] Isolation and characterization of bacterial isolates from agriculture field soil of Roorkee region - Murugalatha N Kannan, Sonam Sethi, Anoop Badoni, Vinay Chamoli and Naveen Chandra Bahuguna. [8] Isolation and characterization of silicate-solubilizing bacteria from paddy rhizosphere (Oryza sativa L.)A Sulizah*1,1, Y S Rahayu1,2 and S K Dewi1,3. [9] Isolation and characterization, production of biofertilizer and its effect on vegetable plants with and without carrier materials Paul Anubrata and Dubey Rajendra [10] Isolation and Identification of Pesticides Degrading Bacteria from Farmland Soil-Md. Atikur Rahman1, ASM Shamsul Arefin2, Otun Saha1, Md. Mizanur Rahaman1* [11] Isolation of Pesticide Degrading Microorganisms from soil -Mohammed Asef Iqbal 1* Bartakke K.V.2. [12] Isolation, Characterization of Zn Solubilizing Bacterium (Pseudomonas protegens RY2) and its Contribution in Growth of Chickpea (Cicerarietinum L) as Deciphered by Improved Growth Parameters and Zn Content-Riffat Yasmin1, Sabir Hussain2, Muhammad Hidayat Rasool1,Muhammad Hussnain Siddique3 , and Saima Muzammil1 [13] Methods of plant transformation –a review,G.Keshavareddy,A.R.V.Kumar ,Vemanna S.Ramu. [14] Screening of bacterial strains for developing effective pesticide-tolerant plant growth-promoting microbial consortia from rhizosphere soils of vegetable fields of eastern Uttar Pradesh, India ,Jay Prakash Verma, Durgesh Kumar Jaiswal & Punkaj Kumar Maurya [15] Soil application of zinc improves growth and yield of tomato ali raza gurmani1, jalal-ud-din, sami ullah khan, rani andaleep†, kashif waseem†, ahmed khan‡ and hadyatullah¶
Copyright © 2023 Fousiya M.B, Dr Nisy S.. This is an open access article distributed under the Creative Commons Attribution License, which permits unrestricted use, distribution, and reproduction in any medium, provided the original work is properly cited.
Paper Id : IJRASET52754
Publish Date : 2023-05-22
ISSN : 2321-9653
Publisher Name : IJRASET
DOI Link : Click Here
Submit Paper Online
